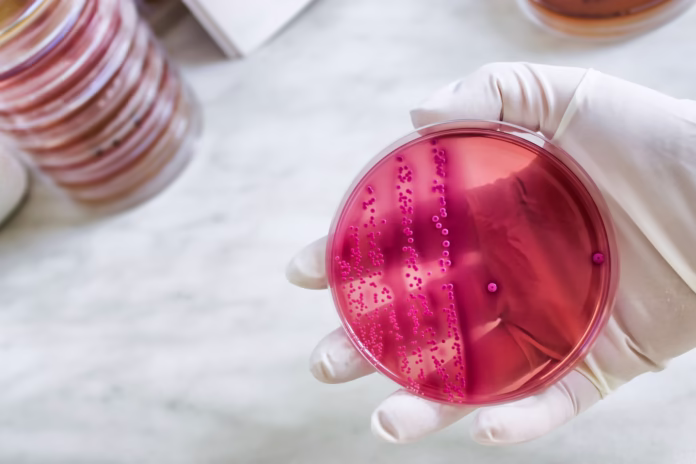

Streptococ A și B – Tot ce trebuie să știi despre aceste bacterii
Streptococii sunt bacterii care fac parte din flora umană, dar unele tipuri pot cauza infecții ușoare sau chiar severe. Cele mai cunoscute tulpini patogene sunt Streptococul de grup A (Streptococcus pyogenes) și Streptococul de grup B (Streptococcus agalactiae), fiecare având manifestări, riscuri și metode de prevenție specifice.
Streptococul de grup A (Streptococcus pyogenes)
Cum se transmite?
Streptococul A se transmite prin:
- picături respiratorii (tuse, strănut)
- contact direct cu secrețiile unei persoane infectate
- obiecte contaminate (jucării, tacâmuri, prosoape)
Este foarte contagios, în special în colectivități (școli, grădinițe).
Simptome frecvente
Infecțiile provocate de streptococul A pot varia de la forme ușoare la boli grave:
- Faringită streptococică (gât inflamat, roșu, dureros)
- Amigdalită purulentă
- Scarlatină (erupție cutanată specifică)
- Otite, sinuzite
- Infecții ale pielii (impetigo, celulită, erizipel)
- Febra reumatică (complicație rară, dar gravă)
În formele severe, poate duce la sepsis, șoc toxic sau fasceită necrozantă.
Streptococul de grup B (Streptococcus agalactiae)
Cum se transmite?
Streptococul B este prezent în mod natural în tractul intestinal, urinar sau genital la unele persoane. Nu provoacă simptome în mod normal, dar poate deveni periculos:
- Pentru nou-născuți, dacă mama este purtătoare și transmite bacteria în timpul nașterii.
- La adulți cu imunitate scăzută, poate provoca infecții urinare, pneumonii, septicemii.
Simptome la nou-născuți și adulți
La nou-născuți, simptomele pot apărea:
- la naștere sau în primele zile de viață (febră, letargie, dificultăți de respirație, alimentație slabă)
- sau mai târziu, în primele 3 luni, și pot include meningită, pneumonie sau septicemie.
La adulți, pot apărea:
- infecții urinare
- infecții ale rănilor
- infecții sistemice la persoanele cu boli cronice
Diagnostic și investigații
Diagnosticul se stabilește prin:
- Teste de exsudat faringian (pentru streptococ A)
- Urocultură sau cultură din secreții genitale (pentru streptococ B)
- Teste rapide de identificare antigenică
- Hemocultură, în cazurile de infecții sistemice
Tratament
Tratamentul se face în general cu antibiotice, în funcție de localizare și severitatea infecției:
Pentru prevenirea transmiterii la nou-născuți, gravidele sunt testate între săptămânile 35-37 de sarcină pentru streptococul B, iar dacă sunt purtătoare, primesc antibiotic intravenos în travaliu.
Complicații streptococ
- Streptococul A poate provoca complicații grave dacă nu este tratat: febră reumatică, glomerulonefrită, infecții invazive.
- Streptococul B este periculos în special pentru nou-născuți, dar și pentru adulții imunodeprimați sau cu boli cronice.
Prevenție și recomandări
- Spălarea frecventă a mâinilor
- Evitarea contactului apropiat cu persoane bolnave
- Evitarea automedicației cu antibiotice
- Respectarea testărilor și tratamentului în timpul sarcinii
- Informarea corectă privind semnele de infecție streptococică.
Streptococii de grup A și B pot părea infecții banale, dar pot evolua spre complicații serioase dacă nu sunt tratate la timp. Consultul medical, testarea corectă și administrarea tratamentului adecvat sunt esențiale pentru prevenirea riscurilor. Nu ignora simptomele și nu amâna vizita la medic!

